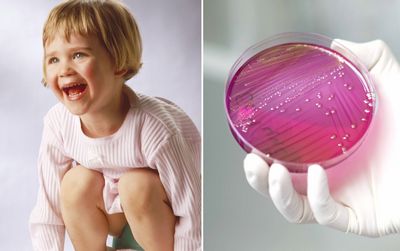
инфекция

Почечная инфекция: причины, симптомы и лечение

(Продолжаемый от страницы 1…)Диагноз почечной инфекцииGP (врач общей практики, врач общей практики) будет обычно проверять частоту сердечных сокращений пациента, кровяное давление, температуру и частоту дыхания, чтобы определить, каково их общее состояние здоровья.
Доктор также проверит на симптомы обезвоживания. …